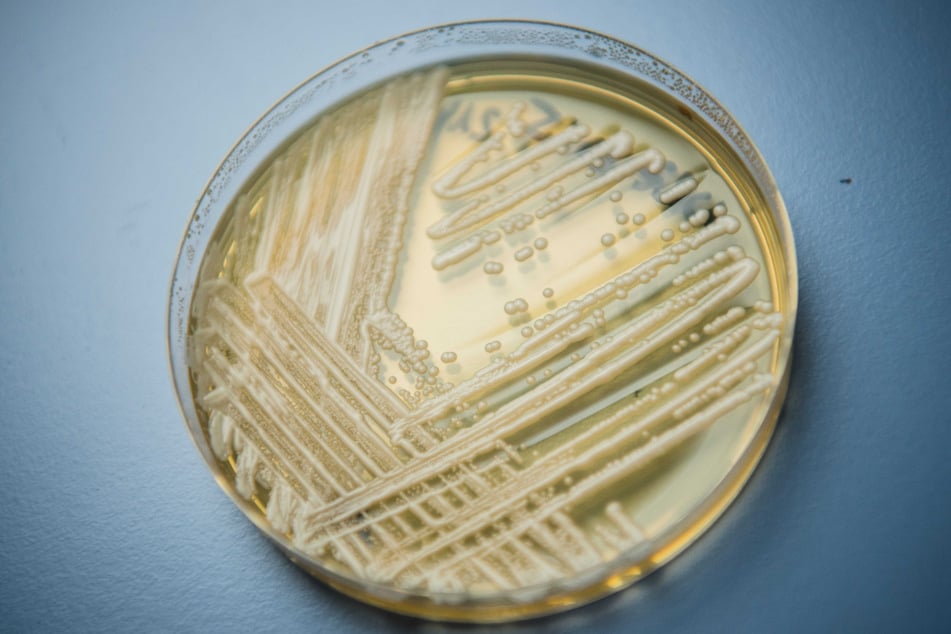
V Německu byl již zaznamenán výskyt patogenu Candida auris. Přesto zatím neexistuje žádný vážný důvod k obavám.

Rezistentní vůči lékům: Nebezpečná houba se šíří po celém světě
Washington/Londýn – V televizním seriálu „The Last of Us“ se po houbové infekci promění nakažení v zombie. My lidé se sice neblížíme tomu, že se změníme v monstra, ale houba odolná vůči lékům vyvolává u vědců stále větší obavy kvůli své šíření. Jedná se o Candida auris. Vědci se touto houbou čím dál více trápí.

Vedle rezistence vůči antimykotikům se patogen také vyznačuje zvýšenou odolností vůči dezinfekčním prostředkům, uvádí Deutsches Ärzteblatt.
Díky svým buněčným stěnovým proteinům může takový houbový patogen přilnout k lidské pokožce a tam přežít, píší výzkumníci v časopise Microbiology and Molecular Biology Reviews.
Pro zdravé osoby je houba neškodná, ale infekce může u starších lidí či novorozenců v nejhorším případě vést k úmrtí. Typické příznaky jsou horečka, zimnice, pocení a bušení srdce, ale také únava nebo kožní vyrážka.
Velké množství pacientů muselo být ošetřováno na jednotce intenzivní péče.
Nemoc se přenáší přímým kontaktem s infikovanou osobou nebo dotykem kontaminované povrchu.
Případy Candida auris: Německo se v celé EU řadí na páté místo.
V roce 2009 byl houba poprvé objevena v uchu japonské pacientky.
Jak uvádí The Sun, bylo v roce 2025 zaznamenáno již 7 000 případů infekcí Candida auris ve 27 různých státech USA – trend stoupá.
Houba se rozšířila i v britských nemocnicích, zejména po zrušení cestovních omezení během pandemie. Německo se v počtu hlášených případů Candida auris řadí na páté místo v Evropské unii, informuje německá tisková agentura DPA.
„Přesto je v Německu tato houba „raritou“,“ uvedl Oliver Kurzai, ředitel ústavu hygieny a mikrobiologie pro spolkovou republiku, a (zatím) vyhlásil situaci za pod kontrolou.